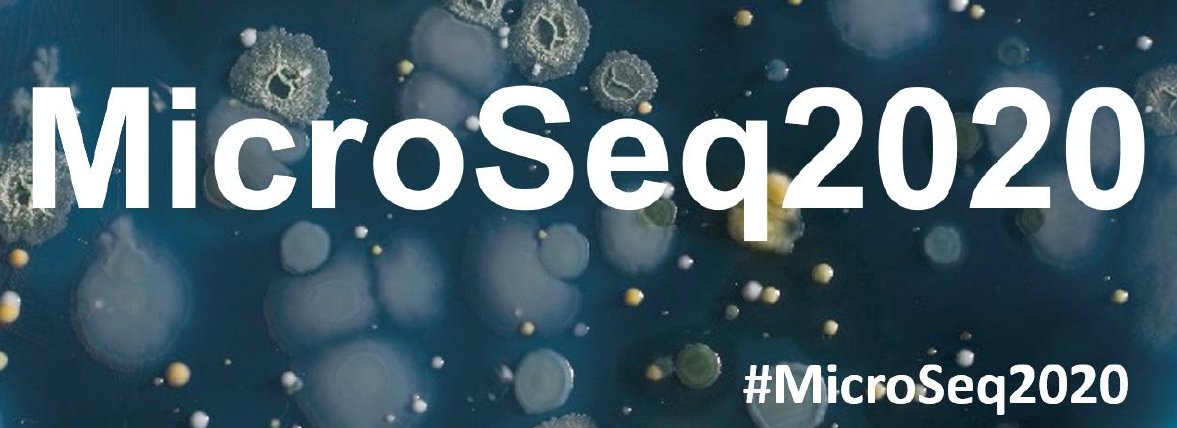
Microbiology, Anatomy, Physiology and Pharmacology tweet media

Sabitlenmiş Tweet

I am so happy to announce the initial release of my qPCR tutorial website! Head over to qpcrtutorial.com to view the online resource!
1/3
English
Matthew Brewer
40 posts

@MattBrewerMicro
Master's of Science student at La Trobe University. LinkedIn: https://t.co/zMuZujZK6S

In 2015 I started a Bachelors degree at this campus without a clue on what a research article even was. Today, I submit a 20,000 word thesis in fulfilment of a Master of Science degree. Thank you @latrobe for this phenomenal journey. I can't wait for my next adventure.








